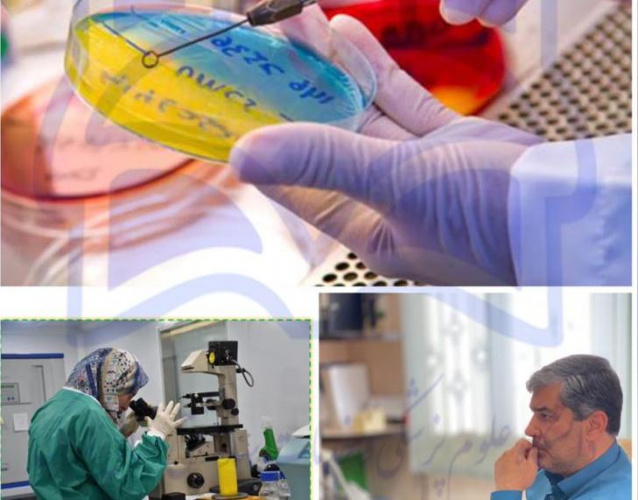
اعطاء موافقت اصولی اولیه به آزمایشگاه همکار غذا و دارو آذین مهر آزما مرکزی

معاون غذا و دارو اراک خبر داد؛
اعطاء موافقت اصولی اولیه به آزمایشگاه همکار غذا و دارو آذین مهر آزما مرکزی
معاون غذا و دارو اراک خبر داد:به همت مدیر و کارشناسان آزمایشگاه کنترل مواد غذایی، آرایشی وبهداشتی، پروانه بهره برداری آزمایشگاه همکار غذا و دارو ، آذین مهر آزما مرکزی موافقت اصولی اولیه را دریافت کرد.
به نقل از روابط عمومی معاونت غذا و دارو اراک، معاون غذا و دارو، دکتر عباس علیمرادیان معاون غذا و دارو اراک اعلام کرد: به همت مدیر و کارشناسان آزمایشگاه کنترل مواد غذایی، آرایشی وبهداشتی، پروانه بهره برداری آزمایشگاه همکار غذا و دارو ، آذین مهر آزما مرکزی موافقت اصولی اولیه را دریافت کرد.
وی افزود: بر این اساس آزمایشگاه همکار آذین مهر آزما مرکزی، مطابق با ضوابط سازمان غذا و دارو در خصوص انجام آزمون های میکروب شناسی مورد تایید می باشد.
انتهای پیام/
رسول غفاری

نظر شما :